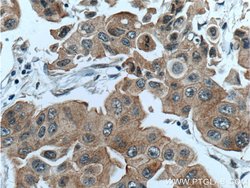
PPP1R13L Rabbit anti-Human, Mouse, Polyclonal, Proteintech 150 &mu;L | Buy Online | Proteintech | Fisher Scientific

missing translation for 'onlineSavingsMsg'
Learn More
Learn More
Description
This gene encodes paired box gene 6, one of many human homologs of the Drosophila melanogaster gene prd. In addition to the hallmark feature of this gene family, a conserved paired box domain, the encoded protein also contains a homeo box domain. Both domains are known to bind DNA, and function as regulators of gene transcription. This gene is expressed in the developing nervous system, and in developing eyes. Mutations in this gene are known to cause ocular disorders such as aniridia and Peter′s anomaly. Alternatively spliced transcript variants encoding either the same or different isoform have been found for this gene.
Specifications
Specifications
| Antigen | PPP1R13L |
| Applications | Immunohistochemistry (Paraffin), Western Blot |
| Classification | Polyclonal |
| Concentration | 0.13 mg/mL |
| Conjugate | Unconjugated |
| Formulation | PBS with 50% glycerol and 0.1% sodium azide; pH 7.3 |
| Gene | PPP1R13L |
| Gene Accession No. | Q5I1X5, Q8WUF5 |
| Gene Alias | IASPP, Inhibitor of ASPP protein, NKIP1, PPP1R13B like protein, PPP1R13BL, PPP1R13L, Protein iASPP, RAI, RelA associated inhibitor |
| Gene Symbols | Ppp1r13l |
| Show More |
Product Title
By clicking Submit, you acknowledge that you may be contacted by Fisher Scientific in regards to the feedback you have provided in this form. We will not share your information for any other purposes. All contact information provided shall also be maintained in accordance with our Privacy Policy.
Spot an opportunity for improvement?